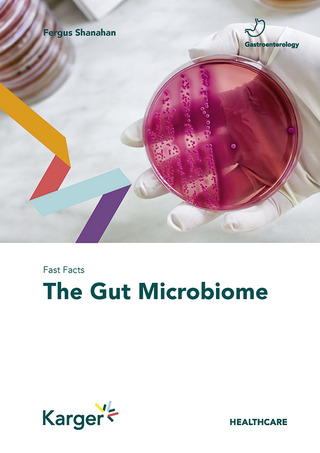
Fast Facts: The Gut Microbiome

eBook Download (PDF)
2025
|
CRC Press
ISBN: 9781040436325
221,07 €
(CHF 215,95) (inkl. MwSt)
(CHF 215,95) (inkl. MwSt)
- Download sofort lieferbar